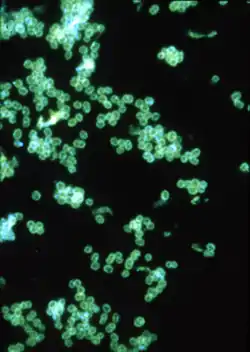

Neisseria
Neisseria (нейсерії) — рід бактерій типу протеобактерій, велика група грам-негативних форм. За формою Neisseria — диплококи, під мікроскопом нагадують кавові боби. Рід включає багато патогенів людини, наприклад:
- N. gonorrhoeae (також називають «гонококом») — спричинює гонорею;
- N. meningitidis (також називають «менінгококом») — спричинює менінгококову інфекцію;
? Neisseria | ||||||||||||
|---|---|---|---|---|---|---|---|---|---|---|---|---|
![]() Імунофлюоресцентне зображення Neisseria gonorrhoeae | ||||||||||||
| Біологічна класифікація | ||||||||||||
| ||||||||||||
Види | ||||||||||||
|
Біля 50 видів. Див. текст і посилання | ||||||||||||
Посилання | ||||||||||||
| ||||||||||||
Рід також включає багато непатогенних видів, наприклад:
- Neisseria cinerea
- Neisseria elongata
- Neisseria flavescens
- Neisseria lactamica
- Neisseria mucosa
- Neisseria polysaccharea
- Neisseria sicca
- Neisseria subflava
Рід названо на честь німецького лікаря і бактеріолога Альберта Нейссера.
Посилання
- Ryan KJ; Ray CG (editors) (2004). Sherris Medical Microbiology (вид. 4th ed.). McGraw Hill. ISBN 0-8385-8529-9.
This article is issued from Wikipedia. The text is licensed under Creative Commons - Attribution - Sharealike. Additional terms may apply for the media files.